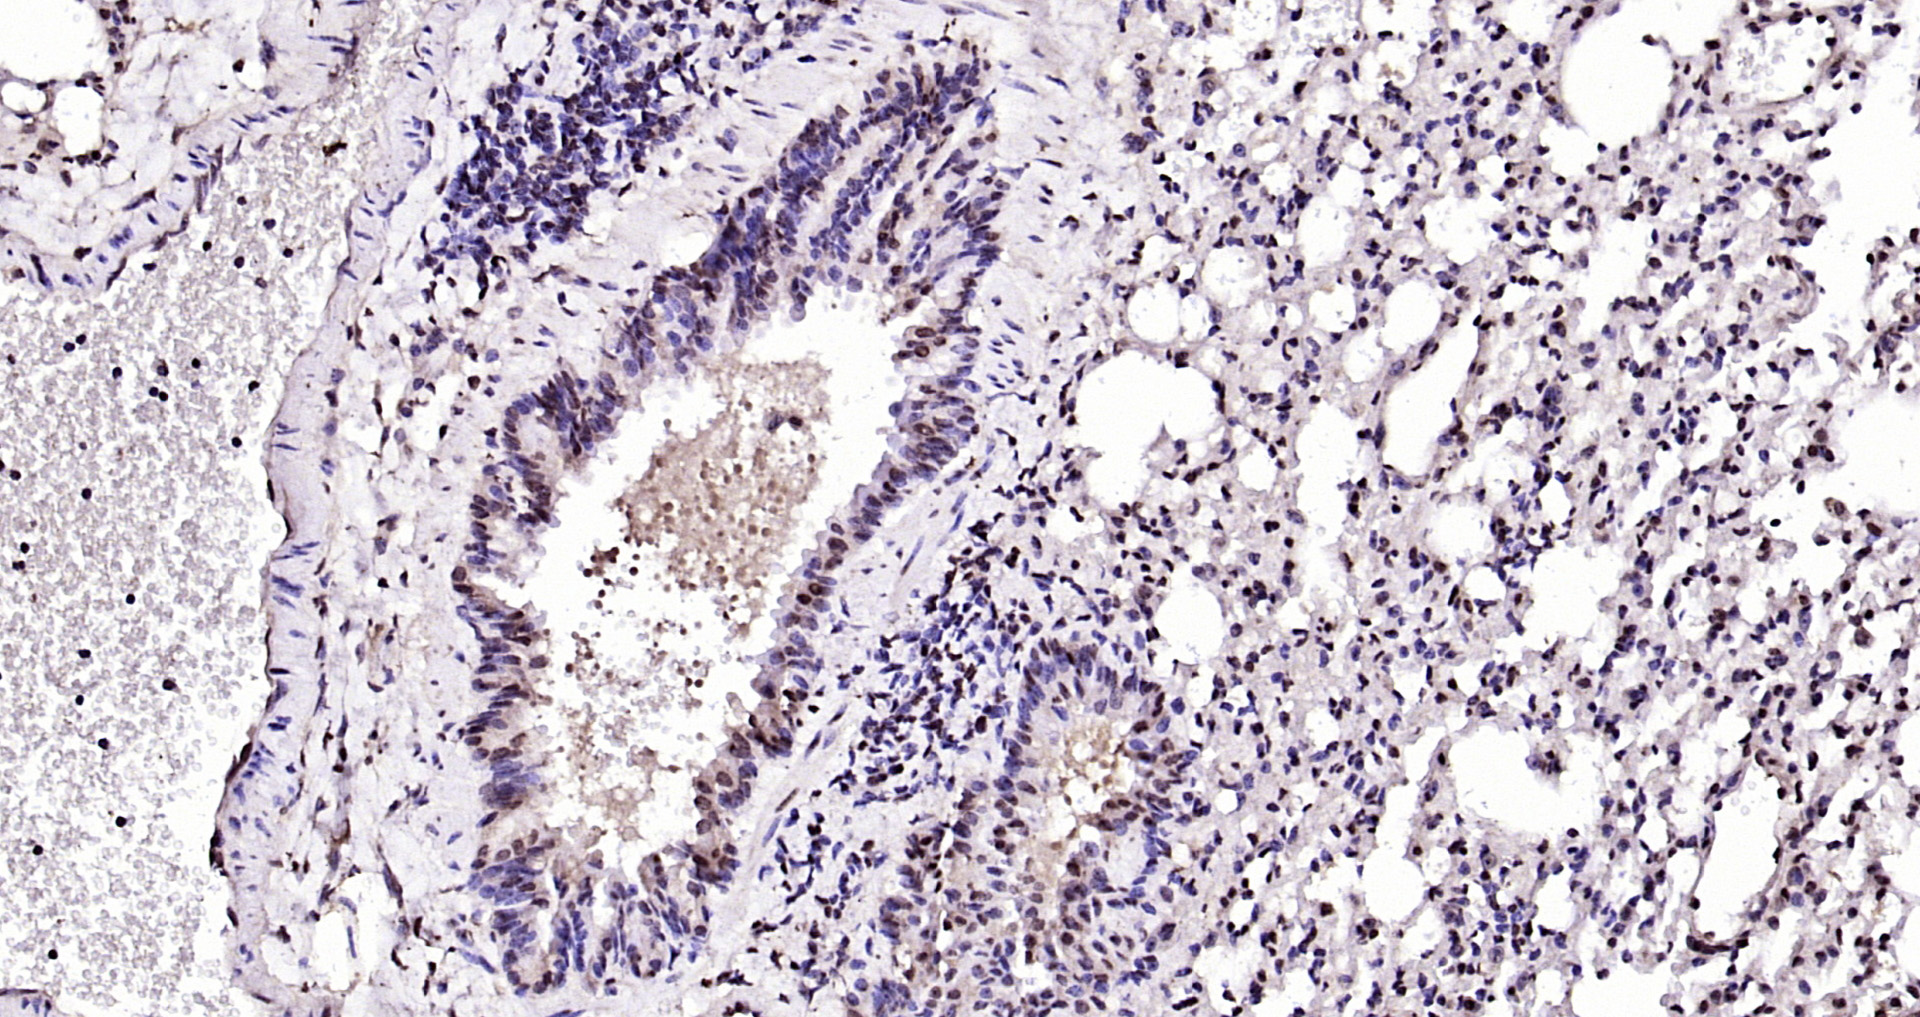

BTG3 Antibody (Preservative Free)
LS-C815535
ApplicationsImmunoHistoChemistry, ImmunoHistoChemistry Paraffin
Product group Antibodies
TargetBTG3
Overview
- SupplierLifeSpan BioSciences
- Product NameBTG3 Antibody (Preservative Free)
- Delivery Days Customer14
- Application Supplier NoteApplications should be user optimized.
- ApplicationsImmunoHistoChemistry, ImmunoHistoChemistry Paraffin
- Applications SupplierIHC-P (1:200 - 1:500) Applications should be user optimized.
- CertificationResearch Use Only
- ClonalityPolyclonal
- ConjugateUnconjugated
- Estimated Purity...
- Gene ID10950
- Target nameBTG3
- Target descriptionBTG anti-proliferation factor 3
- Target synonymsANA, ANA/BTG3, APRO4, TOB5, TOB55, TOFA, protein BTG3, B-cell translocation gene 3, BTG family member 3, abundant in neuroepithelium area protein, protein Tob5
- HostRabbit
- IsotypeIgG
- Storage Instruction-20°C or -80°C,2°C to 8°C
- UNSPSC12352203